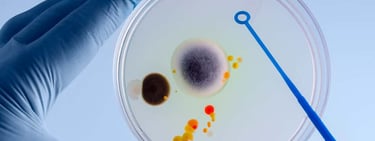
Industria cervecera - Análisis microbiológico - Recuento de Organismos Aerobios Mesofilos

Entregamos servicios y asesorías en aspectos físicos químico y microbiológico para la industria cervecera. Desde el tratamiento de agua como ingrediente, análisis para índices de cervezas terminadas, contenido alcohólico o valor energético.
¿Necesitas tratar el agua de desecho o reutilizarla?, ¿necesitas aprovechar los desechos solidos?... podemos ayudarte en estos y otros aspectos de esta industria.
Cerveza artesanal
(servicios a la industria y artesano)


Análisis de cervezas Terminadas


✔ Grado Alcohólico:
Valor obtenido en laboratorio de manera analítica.
✔ Valor Energético:
Valor obtenido en laboratorio de manera analítica y estimado en base a tablas. Plan de trabajo para más de una variedad. [ver más]
✔ Índice de amargor
Más conocido como IBU, cada año más personas se fijan en este índice.
✔ Acidez Total y Volátil:


Perfil del agua.
Analizamos y medimos el agua con la que trabajarán con el fin de conocer su perfil y posibles tratamientos y adecuación a los requerimientos particulares de tu planta o cerveza en particular.

Eficiencia del Sistema.
Medición de parámetros críticos en puntos de cada proceso para la obtención del agua requerida.
Informes
Análisis de datos acumulados, interpretación de los resultados y recomendaciones de mejoramiento de eficiencia. Acciones a emprender.
Análisis Microbiológico
Ensayo bacteriológico, Coliformes, Coliformes Fecales y Recuento de Aerobios Mesófilos (Análisis RAM).
Otros servicios referidos al agua para cerveza.


Realizamos asesorías en todo lo concerniente al agua como ingrediente principal de la cerveza. Desde perfilar tu agua, como análisis, huella del agua y posibles tratamientos.
Te ayudamos en buscar el mejor sistema de tratamiento pre y post preparación de la cerveza: eliminar un componente no ideal o interferente, agregar otro y hacerte cargo de los RILES de tu planta.
Escríbenos y podemos explicarte más.
Asesorías...
Dirección
San Antonio de Naltahua 6340,
Isla de Maipo, Región Metropolitana
Chile
Contactos
adm@exura.cl
+56 9 3618 1243 (Whatsapp)
+56 9 8273 5651 (Teléfono)


